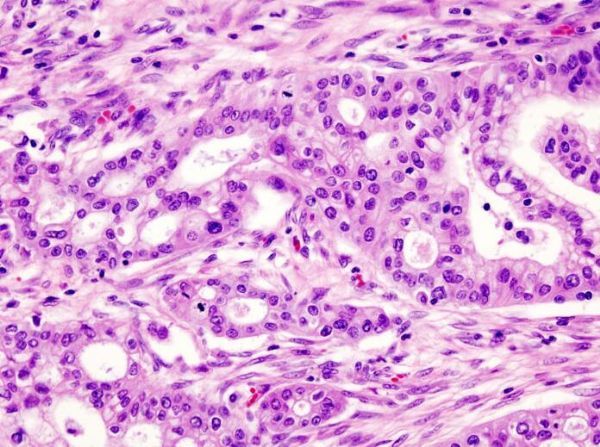

如今,胰腺癌现已经成为全球第七大致死性癌症,患者五年的存活率不到5%。尽管临床医学的发展使很多癌症已经成为了一种可控甚至治愈的疾病,但非常遗憾的是,胰腺癌恰恰是科学家尚未攻克的癌症之一,该病从预防、诊断、治疗到预后效果并不不理想,随着人群生活水平的提高及饮食结构的改变,近年来胰腺癌的发病率呈现上升且年轻化的趋势。
近期胰腺癌领域研究又有哪些突破呢?小编对此进行了整理,分享给各位!
【1】Nature:重磅!揭示贪婪的胰腺癌细胞逃避饥饿机制
doi:10.1038/nature19084
在一项新的研究中,来自美国纽约大学朗格尼医学中心、哈佛大学达纳-法伯癌症研究所和密歇根大学医学院等机构的研究人员通过利用胰腺癌细胞和小鼠开展实验,发现胰腺癌细胞在致密的肿瘤中通过命令附近的支持细胞(support cell,即后面提到的胰腺星状细胞)给它们提供替代性营养来源,从而避免饥饿。相关研究结果于2016年8月10日在线发表Nature期刊上,论文标题为“Pancreatic stellate cells support tumour metabolism through autophagic alanine secretion”。
这些结果围绕着当在正常情形下由血液供应的氧气和血糖(即葡萄糖)处于短缺时,胰腺癌细胞寻找能量的独特能力。这就是肿瘤内异常的细胞生长快速地消耗掉可获得的资源时发生的情形。
这项新研究是首次揭示出胰腺癌细胞发送信号给胰腺星状细胞(stellate cell),然后胰腺星状细胞在胰腺中分泌物质从而为胰腺癌细胞生长提供支持。这会导致胰腺星状细胞将它们自己的细胞组分降解为构造单元,如蛋白的构造单元是氨基酸(如丙氨酸),DNA的构造单元是4种碱基:A、T、C和G。胰腺癌细胞然后将丙氨酸转运到它们的线粒体中,利用它作为替代葡萄糖的能源。

【2】PNAS:二甲双胍联合纳米药物是治疗胰腺癌的好选择
doi: 10.1073/pnas.1611406113
癌症研究人员经过长期观察发现多种抗癌药物组合的治疗效果好于单种药物治疗。最近来自美国约翰斯霍普金斯的科学家们进行了一项研究,他们通过代谢组学的方法追踪癌细胞非常依赖的一些代谢途径,为开发特异性靶向这些途径的抗癌药物组合提供了科学证据,这种药物组合中包括约翰斯霍普金斯研究人员开发的一种纳米颗粒药物。
"我们不能只从一个角度对癌细胞进行打击,在癌症治疗过程中学会如何对药物进行组合靶向正确的信号途径是非常重要的。"约翰斯霍普金斯大学医学院的Anne Le教授这样说道。
相关研究结果发表在国际学术期刊PNAS上。
在这项研究中,研究人员首先从一种叫做BPTES的试验性药物开始,在此之前BPTES已经在多种癌症动物模型中得到检测,都不能帮助减小肿瘤尺寸。科学家们认为这可能是由于在使用传统给药方法的时候肿瘤组织中的药物浓度不够高而导致的。
【3】Cell:免疫细胞“起内讧”或促进胰腺癌恶化
doi:10.1016/j.cell.2016.07.046
日前一项刊登于国际杂志Cell上的一项研究报告中,来自纽约大学医学中心的研究人员通过研究发现,不同类型细胞间的内部冲突或可帮助解释为何免疫系统会奋力识别并且攻击胰腺癌,而遏制这场内讧或许就可以开发出潜在有效的胰腺癌新型疗法。
文章中研究者描述了一种名为“γδT细胞”的特殊类型的免疫细胞,他们发现这类免疫细胞可以帮助抑制其它抵御肿瘤的T细胞进入到胰腺肿瘤内部,如果没有γδT细胞的干预,CD4和CD8细胞就会不断增值并且主动攻击肿瘤,但不幸的是,免疫系统能够产生大量的促肿瘤γδT细胞深入到肿瘤中,并且干扰免疫细胞对肿瘤的攻击。
免疫疗法近年来取得了巨大的进步,即激活患者自身的免疫系统来抵御癌症,从而增强CD4或CD8细胞的活性,本文研究则表明,这种免疫疗法或许就可以靶向应用于胰腺癌的治疗中,除非γδT细胞被阻断,不然CD4和CD8细胞就不能正常发挥功能去遏制癌症发展。研究者George Miller博士指出,标准的免疫疗法或许对胰腺癌并不奏效,尤其是致死性的胰腺癌,如今我们获取了更多信息来解释其原因,机体主要的抗肿瘤防御机制或许在胰腺癌面前完全没有作用。
【4】Nature:挑战常规认知!科学家提出胰腺癌发生新机制
doi:10.1038/nature19823
近日,刊登在国际杂志Nature上的一篇研究报告中,来自加拿大安大略省癌症研究所等机构的研究人员发表了一项最新研究成果,该成果挑战了当前关于胰腺癌为何如此恶性的常规认知,胰腺癌更趋向于在晚期阶段表现出来,研究者目前并不清楚为何很多胰腺癌患者发现疾病时往往是处于癌症晚期阶段。
利用全基因组测序技术,研究小组在100个独立的肿瘤中重建了胰腺癌的发展历程,让研究者不可思议的是,他们发现,很多被认为引发疾病的重要遗传改变实际上会突然发生,就类似于创世大爆炸一样。胰腺癌是一种高度恶性且致死性的癌症,据估计截止到2030年,胰腺癌将成为第二大引发死亡的癌症类型,改善患者的临床预后往往非常困难,这也就强调了深入阐明胰腺癌发病机制的重要性。
研究者Notta博士说道,在很多年前当我们开始研究这个课题的时候,我们就想深入阐明为何在临床上胰腺癌进展如此之快,这种癌症往往起源于局部性病灶,而且仅限于胰腺发病,从而快速开始转移,目前如果不能够将肿瘤的生物学特性同疾病的临床证据相联系的话,研究者一般很难发现胰腺癌的新型疗法,而本文研究中研究者提出了一种不同的方法来揭示疾病的发病机制,同时对疾病相关的临床问题进行深入的剖析,他们希望基于深入的研究后能够解释为何胰腺癌如此具有恶性且进展神速。
【5】Nat Genet:表观遗传变化让远端转移的胰腺癌细胞更具生存优势
doi:10.1038/ng.3753
一项多中心研究报告称,对死于胰腺癌的病人肿瘤样本进行的全基因组分析表明DNA上发生的表观遗传修饰能够使一些胰腺癌细胞获得生存优势,据研究人员介绍,这些优势能够让癌细胞在肝脏和肺这样血液供应充足的器官繁荣生长。相关研究结果发表在国际学术期刊Nature Genetics上。
癌症转移会让癌症变得非常致命,手术和其他治疗方法无法发现并摧毁每一个癌细胞,对于胰腺癌来说尤为如此,在发生转移之前一般很难检测到肿瘤的存在。
为了更好地理解胰腺癌转移灶的形成,纪念斯隆卡特琳癌症中心的研究人员从8位死于胰腺导管腺癌的病人身上收集了肿瘤组织样本,样本取自原位肿瘤和任何可以检测到的转移肿瘤。研究人员对肿瘤的基因组进行了分析,寻找基因突变和DNA上发生的变化,在另外一篇发表的文章中他们报告称并未发现与癌细胞成功转移有直接关联的基因突变。

【6】Nature:附带致死性或有助开发出治疗胰腺癌的新方法
doi:10.1038/nature21052
癌细胞经常剔除在正常情形下抑制肿瘤形成的基因。这些基因剔除可能也会影响相邻的基因,这一事件被称作为“附带致死性(collateral lethality)”。这可能为开发治疗几种癌症的疗法提供新的选择。
在一项新的研究中,来自美国德州大学MD安德森癌症中心的研究人员发现在早期的癌症产生期间,当一种常见的肿瘤抑制基因SMAD4被剔除时,一种相邻的代谢酶基因ME2(编码苹果酸酶2)也会被清除,这提示着苹果酸酶抑制剂可能用作一种新的治疗方法。相关研究结果于2017年1月18日在线发表在Nature期刊上,论文标题为“Genomic deletion of malic enzyme 2 confers collateral lethality in pancreatic cancer”。
论文共同第一作者、德州大学MD安德森癌症中心癌症生物学博士后研究员PrasenjitDey博士说,“在努力将治疗策略从癌基因靶标扩展到与癌症产生不直接相关联的靶标的过程中,我们鉴定出胰腺癌附带致死性的弱点,而且在某些病人群体中能够利用药物靶向这些弱点。针对几种癌症的基因组数据进一步提示着这种治疗策略可能有益于很多癌症患者,包括胃癌患者和结肠癌患者。”
【7】Nature:重磅!鉴定出侵袭性胰腺癌细胞及其弱点
doi:10.1038/nature21064
在一项新的研究中,来自美国德州大学MD安德森癌症中心的研究人员利用病人源性肿瘤异种移植(patient-derived tumor xenograft, PDX)和模式小鼠开展一系列临床前实验,鉴定出一种门卫蛋白(gatekeeper protein)阻止胰腺癌细胞转化为一种极具侵袭性的细胞类型,并且也发现剔除这种门卫蛋白的疗法能够阻止这些癌细胞。这些发现有助为携带这种进展迅速的治疗抵抗性的胰腺癌细胞亚群的病人开发出潜在的疗法。相关研究结果于2017年2月8日在线发表在Nature期刊上,论文标题为“Synthetic vulnerabilities of mesenchymal subpopulations in pancreatic cancer”。
论文共同通信作者、德州大学MD安德森癌症中心基因组医学系讲师Giannicola Genovese博士说,“胰腺癌细胞的特征是显著的可塑性,即让这种恶性肿瘤非常难以治疗的细胞变化。”
Genovese及其团队发现在初始的致癌性驱动基因KRAS消失后,剔除SMARCB1基因会导致一小部分胰腺癌细胞发生变化而进入一种间充质状态(mesenchymal status),即一种可移动的浸润性细胞状态。

【8】Sci Rep:安定药为胰腺癌治疗带来新希望
doi:10.1038/srep39732
导管腺癌是最常见的一种胰腺肿瘤,这种疾病的康复率很低不仅是因为早期诊断存在困难,还因为缺少特异性的药物治疗方法。最近发表在国际学术期刊Scientific Reports上的一项研究为导管腺癌的治疗带来了新的希望。
研究人员发现一种一直用于焦虑症治疗的药物分子能够干扰一种参与癌症发育过程的蛋白分子的活性。这个叫做Nupr1的蛋白与胰腺癌的关系从上世纪90年代就开始得到证明。
“在这项研究中,我们对超过100种已经得到批准用于各种治疗用途的药物分子进行筛选,将实验技术与计算机模拟结合使得我们能够发现一些与Nupr1相互作用的药物。体外实验证明这些筛选出来的化合物能够降低肿瘤细胞的活力,抑制肿瘤细胞的迁移,完全抑制肿瘤细胞的克隆形成能力。我们将最有效的化合物用在异种移植的小鼠模型上证明这种药物能够完全阻止胰腺癌的发展。这种叫做trifluoperazine的分子一直用于焦虑症的治疗,我们证明这种药物还具有抗肿瘤作用,作用效果甚至好于最有效的化疗药物。”文章作者Bruno Rizzuti这样说道。
【9】Cancer Res:天津医科大学教授发现遏制胰腺癌转移潜在靶点
DOI: 10.1158/0008-5472.CAN-16-2170
近日,天津医科大学郝继辉教授带领研究小组在国际学术期刊Cancer Research 上发表了一项最新研究进展,他们在胰腺导管腺癌中发现了一个新的肿瘤抑制因子,并对该分子如何发挥肿瘤抑制作用进行了探讨。
郝继辉教授是天津医科大学肿瘤医院副院长,胰腺肿瘤中心主任,全国胰腺癌诊疗专家组成员。他不仅在临床中做出许多杰出工作,还带领研究团队围绕胰腺癌进行了深入的基础及转化研究。
ESE3是ETS 家族的一个转录因子,在许多上皮组织的分化和发育程序中发挥着重要作用。在这项最新研究中,郝继辉教授等人报道ESE3在胰腺癌中发挥肿瘤抑制因子作用,这是之前研究从未发现过的。他们观察到相比于胰腺导管腺癌周围的正常组织,癌组织中的 ESE3表达水平非常低,并且PDAC 中 ESE3表达水平下降与癌症发生淋巴结转移和脉管侵袭的增加以及病人无复发率和整体生存率下降都存在密切关联。

【10】PNAS:微环境改变胰腺癌细胞表观遗传和代谢 科学家找到解决方法
DOI: 10.1073/pnas.1620164114
就像种子生长需要营养和水分充分的土壤一样,许多癌症都依赖于周围的环境才能在体内繁荣生长。肿瘤微环境在肿瘤生长过程中发挥重要作用。现在科学家们发现了来自微环境的信号如何通过改变癌细胞代谢促进胰腺肿瘤生长。相关研究结果发表在国际学术期刊PNAS上。
胰腺癌病人的五年生存率很低,并且胰腺癌细胞容易对化疗药物和免疫治疗药物产生抵抗,因此开发新的治疗方法有非常重要的意义。
之前有研究表明来自周围基底细胞的信号既包括帮助胰腺肿瘤生长的支持信号也有帮助对抗癌症的抑制信号。为了了解胰腺癌细胞如何利用支持信号,研究人员开发了一种方法模拟胰腺癌细胞如何与基质密切整合从而进行生长。
“我们开发了一个培养系统,这样我们就可以将人类胰腺细胞培养在添加或者不添加基质信号的三维环境中。”文章第一作者Mara Sherman这样说道。(生物谷Bioon.com)
扫描上面二维码在移动端打开阅读








